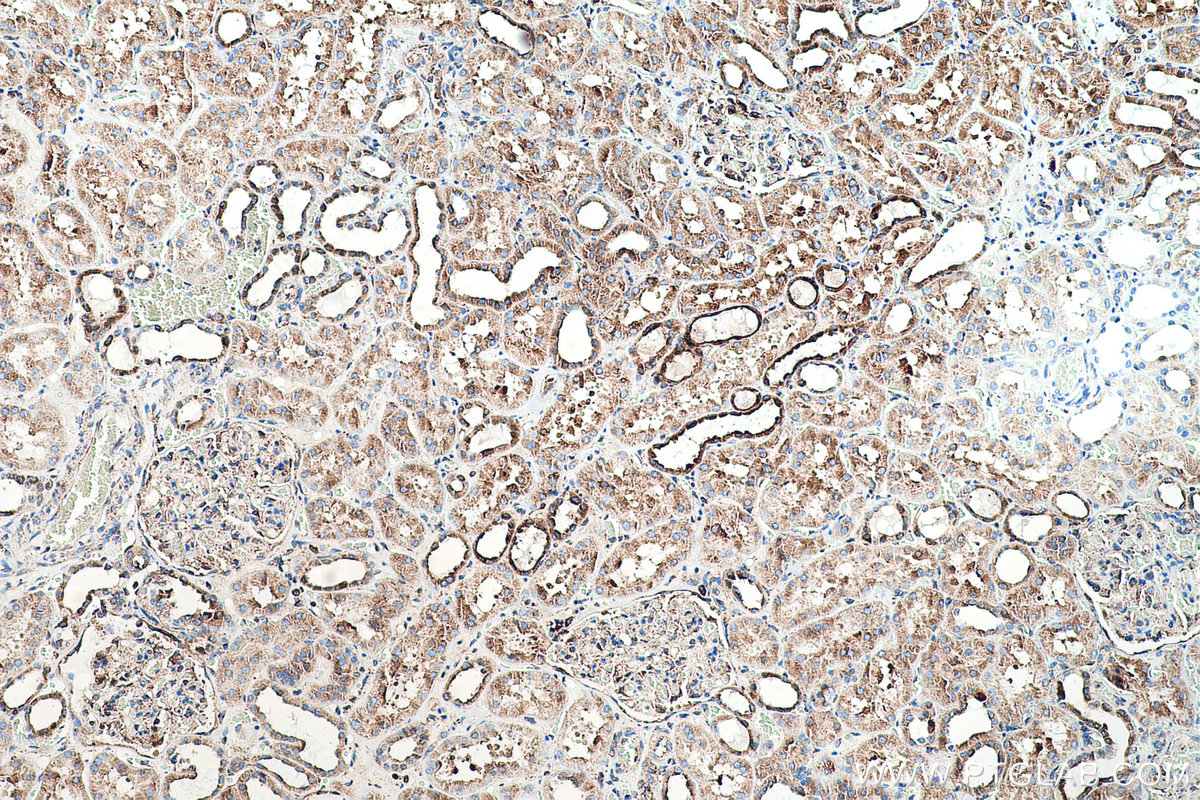

IHCeasy® GRP78/HSPA5 Ready-To-Use IHC Kit
GRP78/HSPA5 Ready-to-use reagent kit for IHC.
Cat no : KHC0509
Synonyms
BIP, FLJ26106, GRP 78, GRP78, Heat shock 70 kDa protein 5, HSPA5, MIF2
Validation Data Gallery
Product Information
KHC0509 is a ready-to-use IHC kit for staining of GRP78/HSPA5. The kit provides all reagents, from antigen retrieval to cover slip mounting, that require little to no diluting or handling prior to use. Simply apply the reagents to your sample slide according to the protocol and you're steps away from obtaining high-quality IHC data.
| Product name | IHCeasy GRP78/HSPA5 Ready-To-Use IHC Kit |
| Sample type | FFPE tissue |
| Assay type | Immunohistochemistry |
| Primary antibody type | Rabbit Recombinant |
| Secondary antibody type | Polymer-HRP-Goat anti-Rabbit |
| Reactivity | Human, Mouse, Rat |
Kit components
| Component | Size | Concentration |
|---|---|---|
| Antigen Retrieval Buffer | 100 mL | 50× |
| Washing Buffer | 100 mL ×2 | 20× |
| Blocking Buffer | 5 mL | RTU |
| Primary Antibody | 5 mL | RTU |
| Secondary Antibody | 5 mL | RTU |
| Chromogen Component A | 0.2 mL | RTU |
| Chromogen Component B | 4 mL | RTU |
| Signal Enhancer | 5 mL | RTU |
| Counter Staining Reagent | 5 mL | RTU |
| Mounting Media | 5 mL | RTU |
| Datasheet | 1 Copy | |
| Manual | 1 Copy |
Background Information
GRP78 (HSPA5), also referred to as 'immunoglobulin heavy chain-binding protein' (BiP), is a member of the heat-shock protein-70 (HSP70) family and is involved in the folding and assembly of proteins in the endoplasmic reticulum. It is a constitutively expressed resident protein of the ER in all eukaryotic cells. Recently it has been reported that GRP78 is associated with apoptosis or inhibition of cancer cell growth.
Properties
| Storage Instructions | All the reagents are stored at 2-8°C. The kit is stable for 6 months from the date of receipt. |
| Synonyms | BIP, FLJ26106, GRP 78, GRP78, Heat shock 70 kDa protein 5, HSPA5, MIF2 |
Publications
| Application | Title |
|---|---|
Life Sci A novel signature of autophagy-related immunophenotyping biomarkers in osteoarthritis |